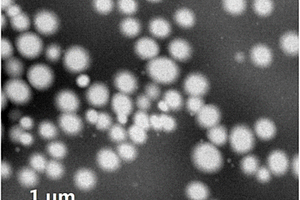

全部

 1003
1003
 0
0
本发明涉及一种智能网络型轨道微环境传感器装置:包括(A)定位轨道,(B)传动模组,(C)环境监测模组组成,其中所述的(A)定位轨道由轨道与无线超音波测距传感器组成,其中所述(B)由传动电机、锰酸锂铁电池、轨道轮组成;其中所述(C)由温度传感器、湿度传感器、CO2传感器、摄像头、WI-FI模块与控制模组组成;其中所述(C)环境监测模组用连接杆与(B)传动模组连接;(B)传统模组的车轮置放与轨道内部;其中所涉及的WI-FI模块将各种传感器的讯号发送到上位机,接受到讯号后,自动计算环境因素,灌溉、补气、调温等决策;本发明提供大棚,植物工厂等设施农业使用,实现智能化移动式环境监测方法。

 1061
1061
 0
0
本发明提供了一种金属半燃料电池电极的制备方法,包括:1)、准备镁银锂铝铈合金,其纯度大于等于99.99%;2)、将合金放入真空感应炉中,在惰性气体保护氛围下熔炼;3)、将熔炼后的镁合金加热到500-650℃,保温1.5-2.5h,再进行至少3次轧制获得电极粗品;4)、将电极粗品根据预设标准进行切割和打磨,再用除油剂进行表面清洁;5)、将电极表面的除油剂洗涤干净,即可获得电极成品。本发明的制备方法可以提高电极的放电效率。

 1129
1129
 0
0
一种中低速电缆巡检机器人控制系统,包括处理器单元、第一高速直流电机、第二高速直流电机、图像采集单元、温度采集单元、信号处理器以及电缆巡检机器人,所述的处理器单元分别与图像采集单元和温度采集单元进行通讯,所述的处理器单元通过锂离子电池单独提供电流进行驱动,所述的处理器单元发出第一控制信号和第二控制信号,由所述的第一控制信号和第二控制信号分别控制所述的第二高速直流电机和第一高速直流电机,其中,通过所述的第一高速直流电机的第二控制信号和通过所述的第二高速直流电机的第一控制信号经过所述的信号处理器合成之后,控制电缆巡检机器人进行运动。本发明采用电缆巡检机器人取代了电缆隧道中人工巡检电缆的方式。

 1196
1196
 0
0
本发明提供了一种复合正极浆料的混料方法,所述正极浆料中包括活性物质A和活性物质B,所述活性物质A为三元材料,所述活性物材料B为磷酸铁锂系材料;所述活性物质A的平均粒径D50为X1,D90为X2,其中X1为2.6‑2.8μm,所述X2=k*X1,所述k为1.3‑1.5;所述活性物质B的平均粒径D50为Y1,D90为Y2,其中Y1为1.2‑1.3μm,所述Y2=m*Y1,所述m为1.3‑1.5;并且所述活性材料A和活性材料B在浆料中的质量比满足以下关系式:A质量/(A质量+B质量)=1‑n*(5X1+X2)/(5Y1+Y2),其中n为调整系数,所述n为0.17‑0.19。当活性材料的粒径范围和质量范围满足本发明提出的关系式时,能够获得相态较为稳定的浆料,颗粒分散性好,浆料稳定状态保持时间长,涂覆性能好。

 1131
1131
 0
0
本发明公开了一种含氟烷基的直链碳酸酯及其合成方法,所述含氟烷基的直链碳酸酯包括烃基氟烷基碳酸酯和双(氟烷基)碳酸酯;所述合成方法,采用一锅法苯酚间接酯交换循环反应,包括如下步骤:(1)一次酯交换反应;(2)二次酯交换反应;(3)分离提纯;(4)苯酚循环利用,得到所述烃基氟烷基碳酸酯和双(氟烷基)碳酸酯。本发明一种含氟烷基的直链碳酸酯的合成方法,采用一锅法苯酚间接酯交换循环反应制备含氟烷基的直链碳酸酯,实现苯酚一次投料,多次循环利用的新工艺;本发明的合成方法,可有效节约原料成本,减少废物和废液的产生,实现绿色循环型生产,产品收率高,纯度达99.9%以上,能够满足锂电池电解液的使用要求。

 890
890
 0
0
本申请公开了一种电池壳体、电池及电池装配方法,属于锂电池技术领域,其中电池壳体包括主壳体,主壳体设有空腔以及连通空腔与外界的第一开口;第一盖体,第一盖体与主壳体连接以封闭第一开口,第一盖体包括朝向主壳体空腔设置的第一盖体本体;正极组件,至少部分正极组件设于第一盖体朝向主壳体空腔的侧面,正极组件包括极柱及热熔胶层,热熔胶层设于第一盖体本体与极柱之间,热熔胶层边缘不超过第一盖体本体边缘,且热熔胶层边缘与第一盖体本体边缘的距离不小于0.1mm;该电池壳体通过控制热熔胶层与第一盖体本体边缘的距离以避免焊接造成热熔胶层熔化变形而带来密封性、绝缘性的不可控制的影响,从而影响电池安全性。

 872
872
 0
0
本发明公开了一种远红外线聚酯细旦ATY丝,包括:聚酯细旦层和远红外线发热层,聚酯细旦层为上层和下层,远红外线发热层设置在聚酯细旦层上层和下层之间;远红外线发热层由竹纤维和红外线丝经纬针织构成,聚酯细旦层上层和下层利用纺丝组件对远红外线发热层进行压合;聚酯细旦层以聚酯切片和添加剂为原料的添加剂为:0.6‑1.2wt%的氧化钛微胶囊0.3‑0.6wt%的氧化铝微胶囊,0.5‑1.1wt%的氯化锂,0.6‑0.8wt%的硝酸锌,0.6‑2.5wt%的分散剂;压合时,纺丝温度280‑300℃,得到具备远红外线发热功效和透气性和舒适度极佳的远红外线聚酯细旦纤维层,在通过卷绕的工艺路线制备得到PDY细旦长丝,后再利用空气变形喷嘴进行空气变形制备ATY空变丝,从而获得一种具备红外线性能的舒适度极佳的远红外线聚酯细旦ATY丝。

 933
933
 0
0
本发明公开了一种耐火材料用硅质改性聚羧酸增强剂及其制备方法,其特征在于:采用胶体二氧化硅、硅酸锂或者其混合物对聚羧酸进行改性,获得含有硅或氧化硅基团的聚合物增强剂,并有过量的硅或者氧化硅存留在体系中。本发明的硅质改性聚羧酸增强剂具有很好的分散性,并提高了添加剂在不定形耐火材料中的流动性,能提高不定形耐火材料力学强度,抑制其在高温下的强度下降。

 1207
1207
 0
0
本发明涉及一种硅烷改性聚醚多元醇共聚物固体聚合物电解质及其制备方法。所述固体聚合物电解质包含:(1)硅烷改性聚醚多元醇共聚物;(2)含锂电解质化合物;(3)任选的交联剂;和(4)任选的催化剂。在本发明中,所述硅烷改性聚醚多元醇共聚物固体聚合物电解质显示良好的电化学稳定性,其电化学窗口大于4.5V,室温离子电导率为1×10‑5S/cm‑1×10‑3S/cm。并且,本发明固体聚合物电解质中形成交联硅氧网络结构,可以得到机械性能良好的均质膜,其机械强度为0.5MPa‑300MPa。

 768
768
 0
0
本申请包括一种低功耗的电池管理系统,具体涉及电池供电电路技术领域。所述系统包括电池供电电路以及接入触发电路;在所述接入触发电路中,目标接入端依次通过目标电容以及目标电阻与第一开关管的栅极连接;所述电池组的正极依次通过第一电阻、第二电阻以及并联的第一开关管和第二开关管接地;所述电池组的正极还通过所述第一电阻连接至所述第三开关管的栅极,所述电池组通过所述第三开关管与所述电池供电电路中的控制芯片以及电池监测芯片连接。上述方案中尽可能避免电池未接入负载或者充电器时锂电池仍然处于放电状态的情况,降低了电池管理系统的功耗,提高了电池的寿命。

 914
914
 0
0
一种连续窑和热处理或者热化学处理方法,属于锂离子电池材料加工领域。连续窑包括窑炉、气流送排装置和气流控制装置。其中气流送排装置和气流控制装置配合,以控制窑炉的炉腔内的气氛。由于气流送排装置中的送气嘴和抽气嘴对置,因此可以形成垂直于窑炉长度方向的横向气流,从而可以使内部气氛保持稳定。

 1081
1081
 0
0
本发明公开了高镍正极材料及其制备方法和应用。其中,该制备方法包括:将高镍正极前驱体材料和锂盐进行混合焙烧,然后利用含有硅溶胶的无机酸溶液对焙烧产物进行洗涤,以便得到高镍正极材料。采用该制备方法不仅可以有效解决正极材料水洗过程中容易出现的凝胶化问题,还能借助无机酸和残留碱反应在正极材料表面形成均匀稳定的无机盐包覆层,同时能够简化生产工艺并大大提高生产效率,使得最终制备得到的高镍正极材料不仅表面残碱量较低,还具有较好的循环性能。

本发明公开了一种基于大数据自学习机制的动力电池的SOC/SOH预测方法,包括:S1、提供动力电池的SOC/SOH的预测模型;S2、基于上一电池组的充放电循环后所得到的修正后模型,在当前电池组的充放电循环开始后测得的到目前为止的V、I、T、σ的测量值,从预测模型中预测当前的SOC~/SOH~;S3、完成一个完整的充放电循环后,基于预测的SOC~/SOH~和实际测出的SOC/SOH对上一循环后的预测模型进行修正;S4、在下一电池组充放电循环中采用修正后的预测模型进行SOC/SOH的预测。本发明能够对动力电池实时运行和健康状况进行监测,且检测过程是一个自动过程,无需人工干预。同时本发明可对突发事件,如锂电池燃烧等进行实时警报处理,提高了动力电池的安全性能。
767
767
 0
0
本发明提供了本发明提供了一种纳米球形四氧化三锰负极材料,其包括以下重量百分比的组分:硫酸锰0.3‑0.7%;碳酸氢铵1.7‑3.4%;去离子水84.3‑86.1%;乙醇11.6‑11.9%。本发明还提供了一种该纳米球形四氧化三锰负极材料的制备方法,包括以下步骤:将硫酸锰、乙醇与50%去离子水配成溶液A;将碳酸氢铵与余下去离子水配成溶液B;将溶液A磁力搅拌1‑6h,边搅拌边滴加溶液B,获得悬浊液C;将悬浊液C依次经过滤、洗涤和干燥制备出MnCO3·xH2O;将MnCO3·xH2O高温煅烧制备出四氧化三锰负极材料。本发明相较于现有技术锂电性能优异,表现出较高的可逆容量与良好的循环稳定性。

 963
963
 0
0
本发明公开了一种氮掺杂多孔碳材料及其制备方法,以油条作为碳源,丝素蛋白和端氨基超支化聚合物(HBP‑NH2)作为氮源,通过四段式高温煅烧和碳酸氢钾活化,得到具有高比表面积和丰富孔隙的氮掺杂多孔碳材料,制备过程简便、成本低廉、易于大规模生产,在锂电池、超级电容器、电极材料、气体吸附分离、储氢及污染气体脱除等方面有重要的应用价值。

 815
815
 0
0
本发明公开了一种抗静电抗菌ABS色母粒,其由以下重量份的原料制成:ABS 140‑150份、聚对苯二甲酸丁二醇酯15‑25份、纳米氧化镁2‑6份、古马隆树脂15‑19份、抗氧剂1076 6‑8份、水玻璃10‑16份、三氟甲基磺酸锂8‑10份、柠檬酸铁2‑6份、二氧化硅5‑9份、氧化锌2‑6份。本发明提供的抗静电抗菌ABS色母粒具有良好的抗静电及抗菌防霉性能,加工成本低,制备工艺简单,当应用于ABS制品的着色时,具有颜色稳定性提高、色差较小的优点,克服了现有ABS色母粒着色时颜色不稳定、色差较大等问题。

本发明公开了本发明一种固态电池用的复合硅烷偶联剂三元复合正极材料,其特征在于:此复合正极材料包括以下材料:三元材料、导电剂、聚偏氟乙烯、聚氧化乙烯以及锂盐,其质量比为:75‑92:1‑10:1‑6:1‑12:1‑7,还公开了一种固态电池用的复合硅烷偶联剂三元复合正极材料的制备方法,还公开了一种固态电池用的复合硅烷偶联剂三元复合正极材料的应用。本发明的优点是:采用硅烷偶联剂处理复合有机电解质的正极浆料,可使无机粉体(正极材料,导电剂)表面有机化,与有机电解质更好的接触,改善复合极片性能,提升正极材料的容量发挥率,且该工艺操作相对简单,生产成本较低,利于批量规模化。

本发明公开了一种以细菌为模板,在细菌表面生长MOF材料并转化为多级多孔碳材料的方法,包括以下步骤:(1)将细菌菌粉分散于前驱体溶液中,依次加入有机配体,可溶性金属盐,混合均匀后密封静置12~24h;(2)将静置后的溶液离心、清洗,得到的沉淀物经干燥、碳化、研磨后,即为所述多级多孔碳材料。本发明还公开了由所述方法制备的多级多孔碳材料及由其制备的锂硫电池和锌空气电池。本发明的多级多孔碳材料的制备方法,以细菌作为生物模板和部分碳源,利用细菌结构结合多孔道的MOF材料构建出多级多孔碳材料,方法极其简单有效。

 860
860
 0
0
本发明提供一种复合负极极片的制造方法,包括以下步骤:往分散介质与分散剂的混合液中先加入纳米硅基材料并溶解,再加入硝酸盐溶液进行超声溶解直至完全分散均匀后作为第一电泳沉积液,将铜箔作为负极置于所述第一电泳沉积液中进行电泳沉积,沉积后进行干燥,得到负极极片;往N‑甲基吡咯烷酮和聚偏氟乙烯的混合液中加入碳材料和导电剂并超声处理得到分散液;往所述分散液中加入硝酸盐溶液并充分搅拌混合后作为第二电泳沉积液;将所述负极极片置于所述第二电泳沉积液中进行电泳沉积,沉积后进行干燥,得到碳/硅基叠层复合负极极片。本发明提供的复合负极极片的制造方法可以提高磷酸铁锂电池的倍率性能。

 1072
1072
 0
0
本发明属于薄膜材料领域,涉及一种铼钨锑复合基柔性压电薄膜的制备方法。本发明提出的制备方法是将苯胺、硝酸铼、钨酸钠、六氟锑酸锂以及纤维素复合,再高温氧化,得复合金属氧化物,再将复合金属氧化物分散在聚甲基丙烯酸甲酯/硅烷偶联剂/丙酮溶液中,然后用甩膜机制膜,退火,得铼钨锑复合基柔性压电薄膜。与现有文献相比,本发明有更好的技术效果,所制备的柔性压电薄膜的压电系数为734pC/N,达常规复合压电材料的7倍以上。

 1060
1060
 0
0
本发明公开了一种超级电容器用石墨烯电极材料以及制备方法,其由以下重量份数的原料制备而成:活性炭3~5份、二氧化钛纳米管1~3分、石墨烯2~5份、二异硬脂酰基钛酸乙二酯4~6份、乙酸乙酯40~50份、碳酸锂1~3份、硫化钴2~4份、氢氧化镍2~4份、三乙醇胺盐1~3份、氯化亚锡5~10份。本发明制得的超级电容器用电极材料具有良好的化学稳定性和电导率,同时比电容和能量密度较高,经处理后的活性炭和二氧化钛纳米管具有良好的分散性和粘附性,与石墨烯及其他原料混合,充分提高活性炭和石墨烯的电导率,改善石墨烯的表面浸润性,是一种综合性能良好的电极材料。

 1208
1208
 0
0
本发明公开了一种反应温度较低、产品收率高的三(三甲基硅基)磷酸酯的制备方法,包括以下步骤:将六甲基二硅氮烷和磷酸二氢铵投入反应釜中,然后向反应釜中加入相转移催化剂,升温至30~78℃,反应过程在惰性气体保护下进行,反应结束后,过滤,得到滤液三(三甲基硅基)磷酸酯粗品;再将滤液精馏,收集馏分得到三(三甲基硅基)磷酸酯。本发明所述的方法收率可达85%以上,经上述方法合成并精馏后得到的高纯度三(三甲基硅基)磷酸酯,可直接用作锂离子电池电解液添加剂。

 1198
1198
 0
0
本发明公开了一种汽车应急启动电源安全管理系统,用于电池组和电瓶夹的管理,包括:控制管理单元、第一可控开关、第二可控开关和第一电流采样;电瓶夹系统,分别与电池组正负极连接;所述控制管理单元分别连接第一可控开关和第二可控开关的控制端;所述第一电流采样串接在充电端负极和电池组负极之间;所述控制管理单元还与电瓶夹系统连接;所述电瓶夹系统还包括电瓶夹状态识别单元和第三可控开关单元;所述第三可控开关单元用于接通或关断电池组的正极输出。通过上述方式,本发明所述的汽车应急启动电源安全管理系统,能够对电池组进行安全管理,延长锂电池使用寿命,能够保障汽车应急启动电源的安全使用,消除安全隐患。

 733
733
 0
0
本发明提供了一种防火免烧陶瓷板及其制作方法,包括:陶瓷板层,由无机高分子耐火陶土复合料、有机高分子纤维、水、耐火料以及其他小料制成,陶瓷板层的一面和/或两面设置有凹凸结构;排水孔,密布在所述陶瓷板层上;所述无机高分子耐火复合料为氧化镁、氧化铝、氧化硅、氧化钙、以及氧化锂中的一种或者多种组合;所述有机高分子纤维包括木纤维、竹纤维以及稻壳中的一种或者多种组合;弱酸料为草酸、磷酸、硫酸亚铁、硫酸钠以及硫酸钙中的一种或多种组合。制作简单;陶瓷板层不含甲醛、不易碎、防火、防水,具有板材的功能,防火等级达到A1级,耐火时限达到120分钟以上;且陶瓷板层的两面平整光滑,可以当做木材、大理石、人造石等使用。

 828
828
 0
0
本发明提供一种耐低温绝缘漆,包括如下重量份数的组分:不饱和聚酯丙烯酸脂树脂36?54份、环氧树脂20?28份、苯乙烯树脂12?23份、丙烯酸树脂14?22份、水杨酸酯5?10份、正辛基三甲氧基硅烷6?10份、聚氧乙烯脂肪醇醚3?8份、二氯乙烷4?8份、氢氧化锂2?6份、钼酸钠4?9份、硼化钛5?9份、二苯甲酮4?8份、矿渣1?3份、γ?甲基丙烯酰氧基丙基三甲氧基硅烷4?8份、6?异丙苯茂铁2?5份、分散剂3?5份、流平剂2?6份、固化剂2?5份。由本发明制备的耐低温绝缘漆的膜性物质的耐弯曲性能好,耐220℃热冲击不开裂;耐低温性能好,综合性能优良,应用前景好。

 1094
1094
 0
0
本发明涉及润滑脂组合物及其制备方法。本发明的润滑脂组合物,以润滑脂组合物的各组分总质量为100%计,包含以下组分:一元有机酸3~11wt%;二元酸0.5~5wt%;氢氧化锂0.3~4wt%;氢氧化钙0.1~1.5wt%;极压抗磨剂0.5~3wt%;油性剂0.1~1.5wt%;减磨剂0.1~3wt%;抗氧剂0.1~2wt%;固体添加剂3~10wt%;基础油60~90wt%,其中,极压抗磨剂为烷氧基磷酸盐类极压抗磨剂,固体添加剂为聚四氟乙烯粉末和三聚氰胺氰尿酸盐的混合物。本发明的润滑脂组合物具有优异的耐磨减磨性和承载性,能源消耗小,特别适合于汽车的轴承和齿轮、钢铁、轨道及其他工业机械设备。

 961
961
 0
0
本发明公开了一种带有照明灯的移动电源,包括:外壳、电池芯、USB接口和照明灯,所述外壳为塑料材质方形,所述电池芯为钴酸锂电电芯,容量大于20000mAh,固定在所述外壳的内部,所述USB接口共两个,分别固定在所述外壳的两侧,所述照明灯为LED照明灯,固定在所述外壳的前端,所述外壳还包括开关,用于控制所述照明灯。通过上述方式,本发明带有照明灯的移动电源具有结构简单、有利于大规模生产、操作简单省力、坚固耐用、容量大可多次充电、带有照明灯可当电灯使用、用途多功能广、方便实用等优点,在带有照明灯的移动电源的普及上有着广泛的市场前景。

 828
828
 0
0
本实用新型公开了一种笔记本电脑,包括掌托,掌托处设置有安装槽,安装槽内可拆卸的安装有触摸板模块。安装槽内设置有第一接触式连接端,触摸板模块上设置有第二接触式连接端,当触摸板安装在安装槽内时,第一接触式连接端与第二接触式连接端相连以提供电源和传输数据。触摸板模块从安装槽内取出时,触摸板模块通过无线连接传输数据。触摸板模块内部设置有锂电池。触摸板模块包括电子板以及贴合在电子板外部的模组外框,模组外框的外部喷涂设置玻璃结构。本实用新型的有益效果是携带使用可以放在电脑槽里正常使用;可随时取出蓝牙连接使用,灵活性强。
中冶有色为您提供最新的江苏苏州有色金属材料制备及加工技术理论与应用信息,涵盖发明专利、权利要求、说明书、技术领域、背景技术、实用新型内容及具体实施方式等有色技术内容。打造最具专业性的有色金属技术理论与应用平台!
 2025年10月23日 ~ 25日
2025年10月23日 ~ 25日  2025年10月31日 ~ 11月02日
2025年10月31日 ~ 11月02日  2025年11月07日 ~ 09日
2025年11月07日 ~ 09日  2025年11月14日 ~ 16日
2025年11月14日 ~ 16日  2025年11月14日 ~ 16日
2025年11月14日 ~ 16日 
